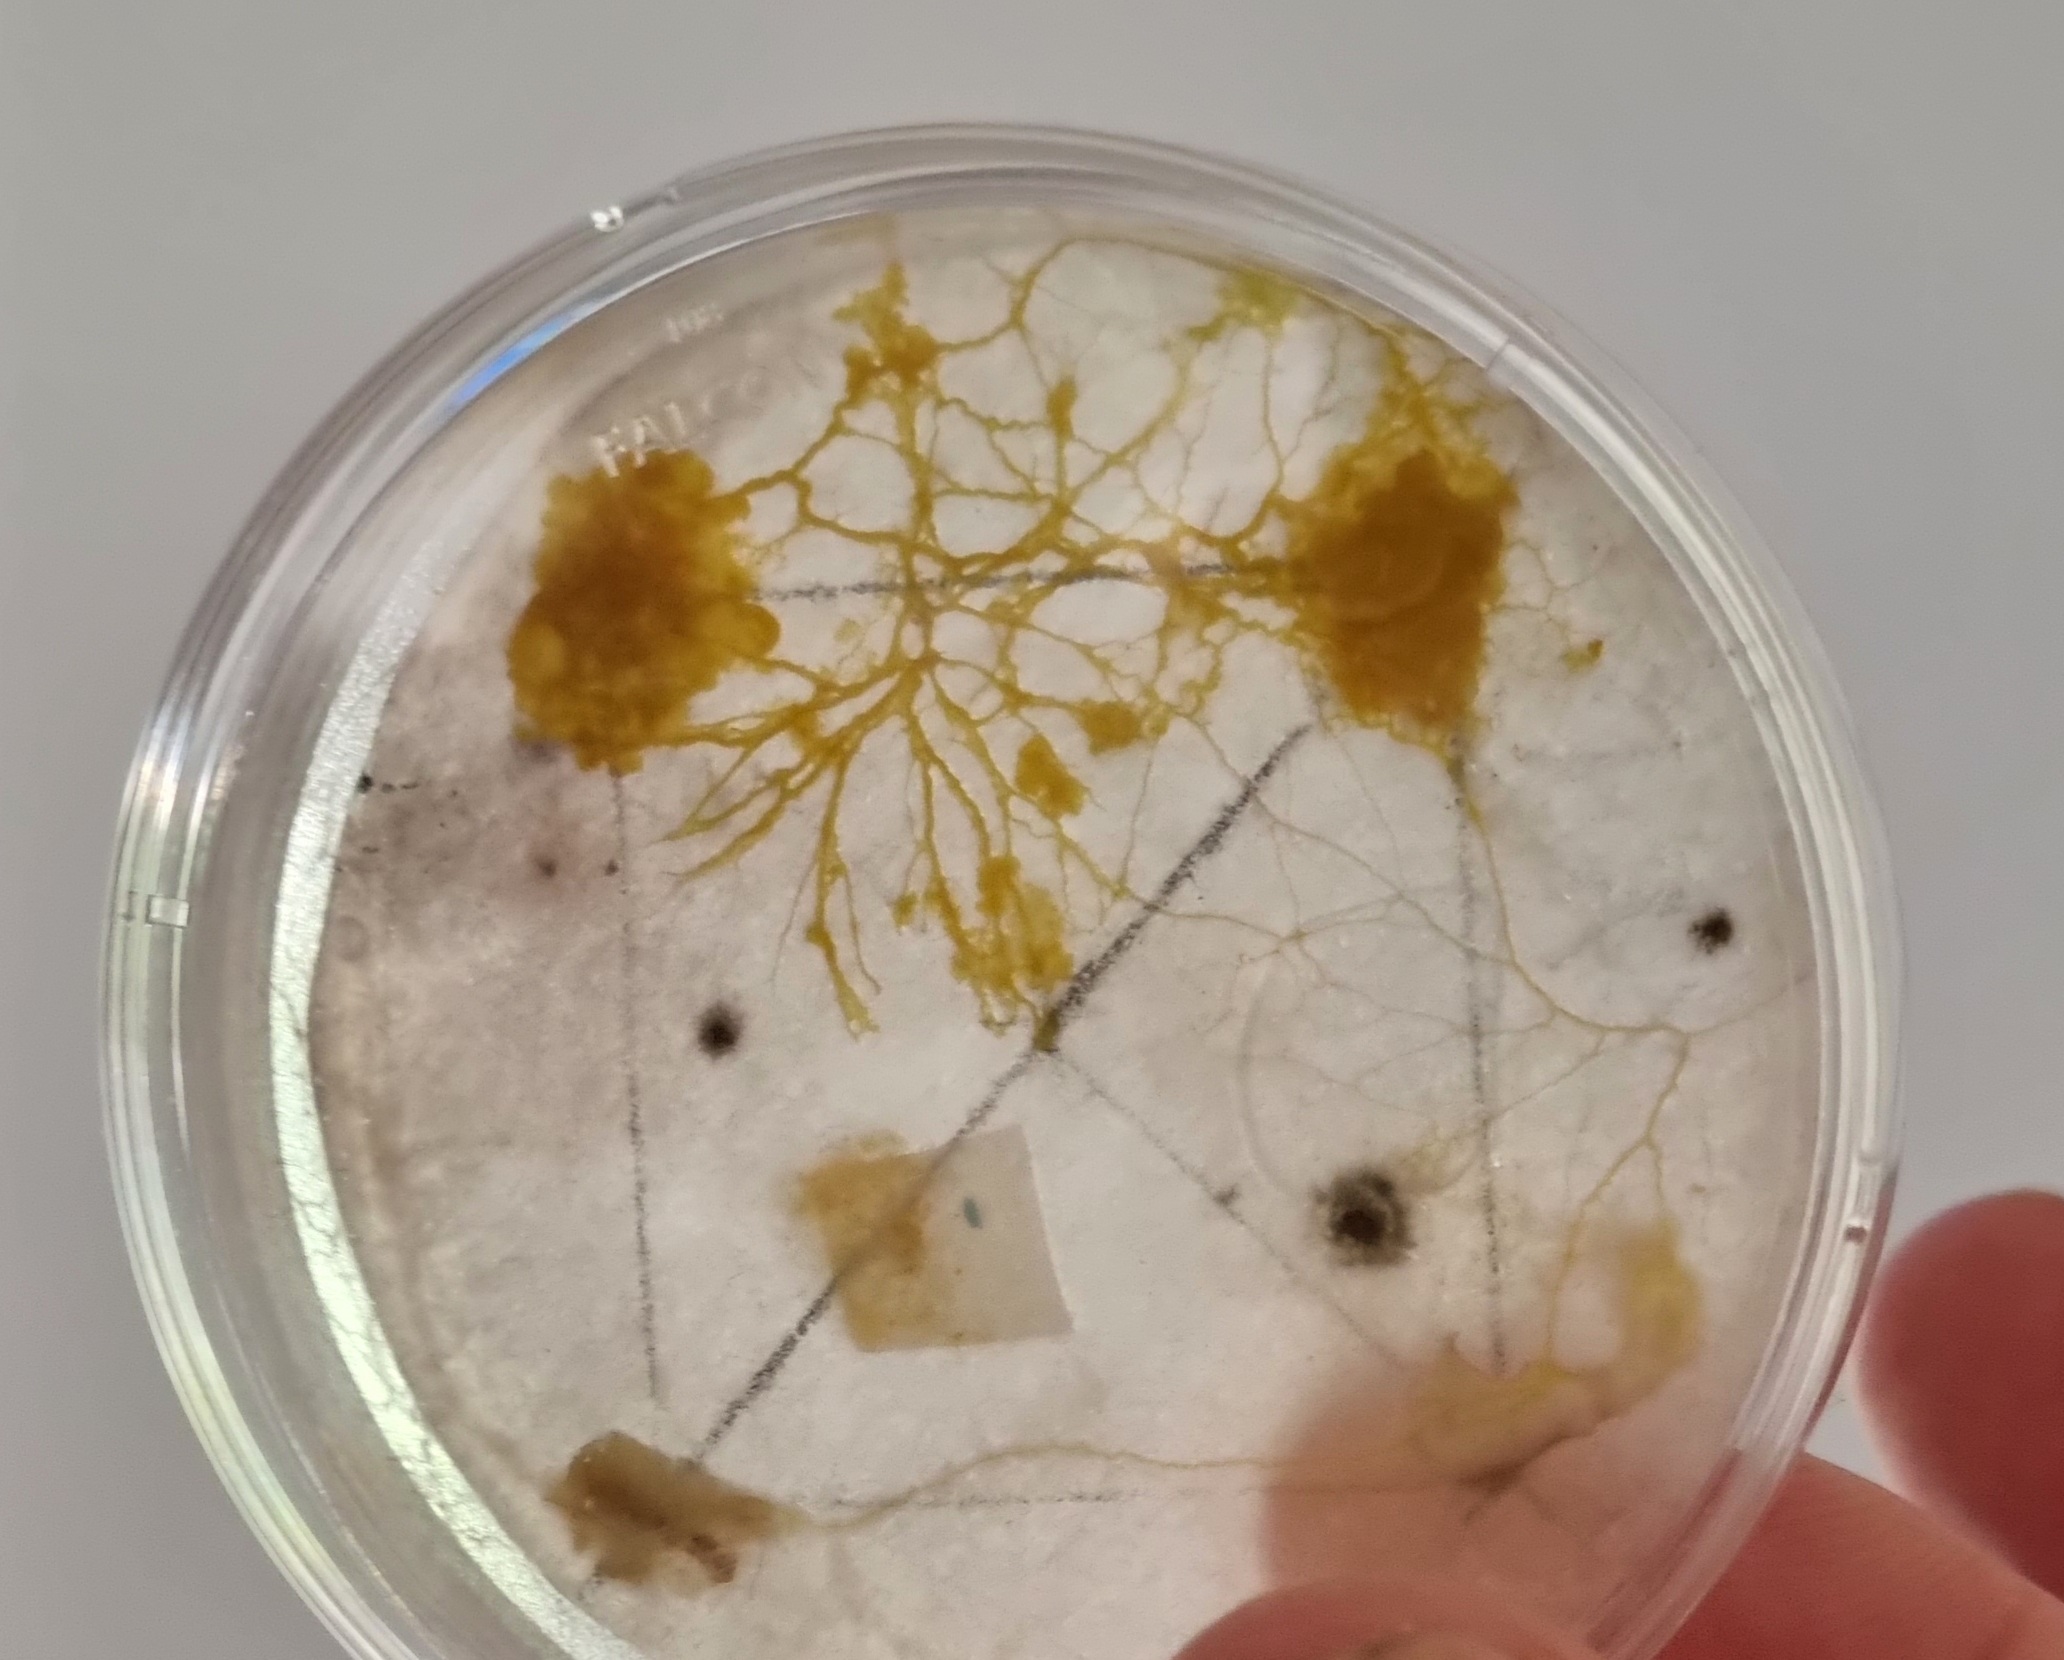

Une année de 2021 de médiation
Une année de médiation scientifique avec le personnel de Genopolys
Rétrospective sur 2021
Décembre 2021
Mercredi 1er Décembre 2021
Rendu du jeu vidéo Blob-trotter par les étudiants d’ARTFX
Cette année de nouveau, Genopolys a proposé aux étudiants d’ARTFX un sujet de jeu vidéo : le blob. Cet organisme surprenant était un sujet parfait pour le workshop de 7 étudiants d’ARTFX. Ils ont travaillé sur le jeu Blobtrotter pendant 2 mois, en lien hebdomadaire avec Magali Kitzmann et Marie Péquignot, pour l’encadrement scientifique et de médiation. Sortie très prochainement !
Mercredi 1er Décembre 2021
Première séance Apprentis Chercheurs 2021/2022 Genopolys.
Les encadrants des 10 équipes de recherche impliquées (IGH, CBS, INM et MMDN), ainsi que des professeurs du lycée Jean Jaurès de st Clément de rivière, et du collège Frederic Bazille de Castelnau le Lez, les 20 apprentis chercheurs et les deux coordinatrices : Magali Kitzmann et Marie Péquignot se sont retrouvés à Genopolys, pour cette première séance de rencontre entre encadrants et Apprentis. Les élèves et leurs encadrants ont ensuite rejoint leurs instituts de recherche, pour une visite Hygiène et Sécurité, puis les jeunes Apprentis ont pu découvrir en détail le projet de recherche sur lequel ils allaient travailler tout au long de cette année.
Jeudi 2 Décembre 2021
Journée « 1 jour, 1 sens : l’audition » à l’école de Lamalou-les-bains.
Magali Kitzmann et Marie Péquignot (Genopolys) et Pierre Rambeau sont allés dans l’école de Lamalou-les-bains (enseignante Esther Benetti) pour une journée sur l’Audition. Après un petit quizz pour faire l’état des lieux des connaissances des élèves, ceux-ci ont pu faire des jeux, de petites expériences et découvrir des notions scientifiques poussées comme la fréquence et l’intensité d’un son, le nom de chaque partie de l’oreille (tympan, cochlée et ses cellules ciliées, les osselets, qu’ils ont pu voir en vrai). Les élèves ont reçu un petit carnet d’expérience qu’ils ont rempli au fur et à mesure de la journée. En fin de journée, ils ont pu voir, en répondant qu même petit quizz que le matin, qu’ils avaient appris plein de choses ! Rendez-vous dans 2 mois pour une journée sur la vision, et pour un petit bilan de ce qu’ils auront retenu de cette première journée !
Vendredi 3 Décembre 2021
Journée « 1 jour, 1 sens : l’audition » à l’école du Bousquet d’Orb.
Magali Kitzmann et Marie Péquignot (Genopolys) et Pierre Rambeau sont allés dans l’école du Bousquet d’Orb (enseignant Ahmed Selmani) pour une journée sur l’Audition. Comme à l’école de Lamalou-les-bains, ils ont été accueillis avec enthousiasme par les élèves qui ont pu découvrir l’oreille comme ils ne l’avaient jamais vu. Rendez-vous dans 2 mois pour une journée sur la vision, et un petit bilan de ce qu’ils auront retenu de cette première journée !
Lundi 6 à mercredi 8 Décembre 2021
Congrès de l’AMCSTI à Lyon
Magali Kitzmann et Marie Péquignot (Genopolys) ont participé au congrès de l’AMCSTI, le réseau national des professionnels des cultures scientifique, technique et industrielle (CSTI). L’occasion de rencontrer les acteurs de médiation scientifique de la France entière et de découvrir les actions qu’ils mènent. 3 jours d’échanges et de découvertes dans le Musée des Confluences de Lyon et au Planétarium de Vaulx en Velin.
Jeudi 9 Décembre 2021
Journée « 1 jour, 1 sens : l’audition » à l’école de Prémian
Magali Kitzmann et Marie Péquignot (Genopolys) et Pierre Rambeau sont allés dans l’école de Prémian (enseignant Roland Coutou) pour une journée sur l’Audition. Les élèves, du CE2 au CM2, ont pu découvrir l’anatomie de l’oreille et son fonctionnement, mais également comment protéger son ouïe pour ne pas devenir sourd prématurément. Rendez-vous dans 2 mois pour une journée sur la vision, et pour un petit bilan de ce qu’ils auront retenu de cette première journée !
Lundi 13 Décembre 2021
Formation pour les encadrants Apprentis Chercheurs
Magali Kitzmann et Marie Péquignot (Genopolys), assistées de Pierre Rambeau, ont animé une formation pour les encadrants des instituts de Montpellier (et de Toulouse) participant au programme Apprentis Chercheurs. Les stagiaires ont pu expérimenter un jeu permettant de ressentir l’incompéhension, s’entrainer à expliquer leur sujet de recherche avec des mots simples, en faisant attention aux mots à double sens et en s’aidant de comparaisons pour expliquer les mots compliqués mais indispensables. Ils ont également réfléchi aux différents formats de médiation ainsi qu’aux buts de celle-ci. Cette matinée comptait pour 5h de formation doctorale pour les nombreux doctorants parmi les stagiaires.
Mercredi 15 Décembre 2021
Réunion du Consortium SPEEDING ARROW
L’ensemble des participants du projet SPEEDING ARROW s’est réuni en partie à Genopolys en présentiel et par visioconférence afin de faire le point sur les avancées du projet.
Coordinatrice : Marie Péquignot (Chercheuse et Médiatrice scientifique, Genopolys, INM)
Equipe pédagogique : Pierre Rambeau (docteur en sciences et médiateur scientifique), Chantal Cazevieille (Ingénieure de Recherche Université Montpellier, responsable de la plateforme Microscopie Electronique, INM)
Infographie : Muriel Asari (Ingénieure d’études, Genopolys, IGF)
Equipe Poisson-zèbre : Mireille Rossel (Maitre de Conférence EPHE, MMDN), Nicolas Cubédo (Assistant Ingénieur Université de Montpellier, reponsable de l’animalerie posson-zèbre, MMDN), Jérome Sarniguet (Ingénieur d’études Inserm, responsable de la plateforme Zebrasens, MMDN)
Equipe Poulet : Sandrine Faure (Chercheuse CNRS, chef d’équipe PHYMEDEXP), Pascal de Santa Barbara (Chercheur Inserm, chef d’équipe PHYMEDEXP),
Equipe Souris : Frédéric Michon (Chercheur Inserm, chef d’équipe INM), Alison Kuony (post-doctorante CNRS, INM)
Equipe Humain : Audrey Lamouroux (Médecin, CHU Montpellier), Renaud Lebrun (Ingénieur de Recherche CNRS, responsable de la plateforme Microtomographie, ISEM), Guillaume Captier (Médecin, CHU Montpellier, LIRMM), Christophe Goze-Bac (Chercheur CNRS, responsable de la plateforme BioNanoNMRI)
Jeudi 16 Décembre 2021
Journée « 1 jour, 1 sens : l’audition » à l’école de Saint Saturnin
Magali Kitzmann et Marie Péquignot (Genopolys) et Pierre Rambeau sont allés dans l’école de Saint Saturnin (enseignante Véronique Singla) pour une journée sur l’Audition. Les élèves, de CE2, CM1 et CM2, ont appris comment marchait leurs oreilles et comment les protéger. Chaque élève a reçu un petit carnet d’expériences qu’il a rempli au fur et à mesure de la journée et de ses découvertes. Comme toujours, le jeu de la chauve-souris, qui permet de comprendre l’écholocation et la notion de fréquence, a été repris avec enthousiasme dans la cour de récréation ! Rendez-vous dans 2 mois pour une journée sur la vision, et pour un petit bilan de ce qu’ils auront retenu de cette première journée.
Vendredi 17 Décembre 2021
Journée Escape Game « Sens Dessus Dessous » de Genopolys
L’escape game « Sens dessus dessous » a été créé par Marie Péquignot et Magali Kitzmann fin 2019 et début 2020, à la suite des ateliers sur les sens. Avec la crise sanitaire, les occasions de le faire tester avait été rares. Il a été sélectionné par un appel d’offre Qualité de Vie au Travail du CNRS comme outil de Team building après la pandémie. Ce jour, il a été testé pour la première fois par 2 équipes à la suite.
Novembre 2021
Réunions du Projet SPEEDING ARROW
Tout le long du mois de novembre, Marie Péquignot (Genopolys) et Pierre Rambeau (docteur en science en reconversion en médiation scientifique) ont organisé des réunions avec les participants du projet SPEEDING ARROW : ce projet sur le thème du développement embryonnaire comparé va permettre à 16 personnels de recherche d’aller à la rencontre de lycéens pour 10 séances d’observation et de séminaires. L’occasion pour les jeunes de découvrir des gens passionnés et passionnants, de parler des différents métiers de la recherche, de démarche scientifique, mais aussi d’expérimentation animale.
Mercredi 10 Novembre 2021
Première réunion du projet Apprentis Chercheurs 2021/2022 Genopolys.
10 équipes de recherche impliquées (IGH, CBS, INM et MMDN), le lycée Jean Jaurès de st Clément de rivière, le lycée Jean Monnet de Montpellier et le collège Frederic Bazille de Castelnau le Lez, donc 20 apprentis chercheurs, deux coordinatrices : Magali Kitzmann et Marie Péquignot. La sélection des lettres de motivation des collégiens et des lycéens a été studieuse, le calendrier sur l’année a été posé et le congrès Apprentis Chercheurs est prévu pour le 8 juin 2022.
Les 16, 17 et 18 Novembre 2021
Formation « Osez la médiation scientifique » pour le personnel CNRS proposée par la formation permanente de la Délégation Occitanie Est avec comme formatrices Magali Kitzmann et Marie Péquignot, 6 personnels de recherche ont suivi cette formation. L’auditoire en charge d’écouter et de donner des conseils sur les projets de médiation scientifique proposés par les stagiaires était composé de : Fanny Verhille, responsable de la formation à la délégation Occitanie Est ; Maé Decollogne assistante de communication dans le service communication de la délégation Occitanie Est ; Camilla Frattini indépendante de la médiation scientifique et Lara Montigny titulaire d’un Master 2 en médiation scientifique. Ces projets étaient de grande qualité et méritent d’être portés à terme !
Ce fut l’occasion de tester l’escape game « sens dessus dessous » de Genopolys et de vérifier que cet escape game était bien un bon outil de team building (qualité de vie au travail du CNRS)
Vendredi 26 Novembre 2021
Huitième séance du projet #EleveTonBlob
Une huitième séance s’est déroulée à St Paul et Valmalle en présence de Dorothée Varachat et des enfants de CM1/CM2 avec pour l’animation : Marie Péquignot et Magali Kitzmann, de Genopolys, Chantal Cazevieille, de l’INM, et Pierre Rambeau, pour analyser les images prises lors des expériences nationales. Le protocole EXPLOITATION a été analysé par les élèves de CM2 : le but de l’analyse était de comprendre comment le blob se déplace, en pesanteur normale, en présence de 4 sources de nourriture (flocons d’avoine) et comment il les exploite en créant un réseau le plus efficace possible. Le protocole EXPLORATION a quant à lui été analysé par les élèves de CM1 : cette fois-ci, le blob n’a pas de nourriture à sa disposition, le but est donc d’analyser ses déplacements à la recherche de celle-ci, et de noter en particulier au bout de combien de temps il s’arrête. Ces analyses ont été menées par les élèves sur le logiciel ImageJ, qu’ils avaient appris à utiliser dans une séance précédente.
Mardi 30 Novembre 2021
Neuvième séance du projet #EleveTonBlob
La neuvième séance s’est déroulée à St Paul et Valmalle en présence de Dorothée Varachat et des enfants de CM1/CM2 avec pour l’animation : Marie Péquignot et Muriel Asari, de Genopolys, Chantal Cazevieille, de l’INM, et Pierre Rambeau. Le but de cette séance était d’apprendre aux élèves à utiliser un logiciel de diaporama pour présenter tout ce qu’ils ont appris et leurs résultats, (selon l’évolution de la crise sanitaire) à leurs parents et à des collégiens du collège de secteur, dans le cadre des échanges écoles-collège. Les groupes de 2 ou 3 élèves ont choisi un thème parmi toutes les notions découvertes lors des séances précédentes et ont créé 2 à 3 diapositives, en insérant des photos voire des films. Un premier pas dans la création de diaporama qui leur sera très utile au collège.
Octobre 2021
Mardi 5 Octobre 2021
Cinquième séance du projet #EleveTonBlob
Une cinquième séance s’est déroulée à St Paul et Valmalle en présence de Dorothée Varachat et des enfants de CM1/CM2 avec pour l’animation :Marie Péquignot, Magali kitzmann de Genopolys, Chantal Cazevieille de l’INM et Pierre Rambeau (docteur en science en reconversion en médiation scientifique), pour permettre aux enfants d’utiliser le logiciel image J pour l’analyse des images (pour les futures explorations et exploitations de monsieur Blob). Séance très studieuse, on fait de la vraie science…
Jeudi 7 Octobre 2021
Dans le cadre de l’année de la biologie du CNRS, Magali Kitzmann a donné une conférence à la faculté d’éducation de Montpellier sur la thématique des idées recues en biologie.
Samedi 9 Octobre 2021
La murder party conçue par Jean-Christophe Perez, Morgane Garreau et Amandine Amalric a été réadaptée (Marie Péquignot et Magali Kitzmann) pour le grand public et a été proposée à 6 groupes de 8 personnes (public familial) pour la fête de la science, le 9 octobre 2021 sur le campus CNRS route de Mende à Montpellier lors de l’ouverture au public du campus pour l’évènement « en quête de sciences » organisé par la délégation Occitanie Est du CNRS (https://www.occitanie-est.cnrs.fr/fr/evenement/fete-de-la-science-2021). Merci à Gabrielle Péquignot, Eric Blanchardon et Cyliane Coquelle pour leur aide dans l’animation, et Aline Péquignot pour l’accueil des joueurs.
Lundi 11 Octobre 2021
Sixième séance du projet #EleveTonBlob
Une sixième séance s’est déroulée à St Paul et Valmalle en présence de Dorothée Varachat et des enfants de CM1/CM2 avec pour l’animation :Marie Péquignot, Magali kitzmann et Muriel Asari de Genopolys, Chantal Cazevieille de l’INM et Pierre Rambeau, pour permettre aux enfants de lancer la grande expérience nationale (exploration et exploitation), mais également de tester de nombreux aliments pour savoir ce que le blob préfère.
Samedi 16 et dimanche 17 Octobre 2021
Genopolys (Magali Kitzmann et Marie Péquignot et Muriel Asari le 16 octobre) était à Futurapolis Santé (organisé par la métropole de Montpellier et le journal Le Point) pour un stand sur le blob (avec la présence des enfants de la classe de l’école Suzanne st Julien de st Paul et Valmalle qui participe au projet #Elevetonblob) et un stand Science en jeux avec la présentation des jeux vidéo réalisés avec ArtFX ainsi que le jeu numérique « L’anniversaire de papy en temps de pandémie ».
Lundi 18 Octobre 2021
Septième séance du projet #EleveTonBlob
Une septième séance s’est déroulée à St Paul et Valmalle en présence de Dorothée Varachat et des enfants de CM1/CM2 avec pour l’animation : Marie Péquignot, Magali kitzmann et Muriel Asari de Genopolys et Pierre Rambeau, pour permettre aux enfants de voir les photos prises lors la grande expérience nationale (exploration et exploitation). Les 1044 photos vont être montées en film et certaines d’entre elles serviront à effectuer des mesures), mais également regarder vers quels aliments le blob s’est précipité ou pas (les résultats sont surprenants et méritent d’etre répétés).
Septembre 2021
Mercredi 1er Septembre 2021
Muriel Asari, responsable communication à l’Institut de Génomique Fonctionnelle (IGF) de Montpellier commence à travailler à Genopolys en appui communication aux projets de médiation scientifique de Genopolys.
Vendredi 3 Septembre 2021
La Murder Party a été proposée aux étudiants du Master qBio, dans le cadre de leur « bootcamp ». La préparation de cette Murder Party a nécessité de nombreuses réunions depuis le mois de mai 2021 entre les responsables pédagogiques du master (Luca Ciandrini, Cherine Bechara, Anna-Sophie Fiston-Lavier et Mathieu Ingouff), Genopolys (Magali Kitzmann et Marie Péquignot) et Jean-Christophe Perez, Morgane Garreau et Amandine Amalric.
La Murder Party a duré deux heures, les étudiants ont su déjouer les pièges :
Mardi 7 Septembre 2021
Démarrage du projet #EleveTonBlob
Marie Péquignot (Genopolys) a pris contact avec l’école Suzanne St Julien (enseignante Dorothée Varachat) du village St paul et Valmalle pour participer au projet élève ton blob (avec 4500 autres classes en France) organisé par le CNES, le CNRS et l’académie de Toulouse.
Une première séance s’est déroulée à St Paul et Valmalle en présence de Dorothée Varachat et des enfants de CM1/CM2 avec pour l’animation :Marie Péquignot, Magali kitzmann et Muriel Asari de Genopolys et Chantal Cazevieille de l’INM, pour permettre aux enfants de savoir ce qu’est un etre vivant, le blob est vivant!
Jeudi 9 Septembre 2021
Magali Kitzmann et Marie Péquignot de Genopolys ont concu un escape game : « Why is the delta variant the master of the world? » dans lequel les étudiants du master qBio par équipe suivent le cycle d’infection du variant delta du Sars-Cov2 dans une cellule et doivent résoudre des énigmes leur permettant d’arriver jusqu’aux nouveaux virions, capables d’infecter d’autres cellules. L’escape game a duré 2h, suivi d’un debriefing de 2h, pour comprendre les mutations du delta qui augmentent son infectiosité, sa liaison au récepteur ACE2, sa fusion avec la membrane cellulaire etc…
La préparation de cet Escape Game a nécessité de nombreuses réunions depuis le mois de mai 2021 entre les responsables pédagogiques du master (Luca Ciandrini, Cherine Bechara, Anna-Sophie Fiston-Lavier et Mathieu Ingouff) et Genopolys (Magali Kitzmann et Marie Péquignot).
Lundi 13 Septembre 2021
Deuxième séance du projet #EleveTonBlob
Une deuxième séance s’est déroulée à St Paul et Valmalle en présence de Dorothée Varachat et des enfants de CM1/CM2 avec pour l’animation : Marie Péquignot, Magali kitzmann et Muriel Asari de Genopolys et Chantal Cazevieille de l’INM, pour permettre aux enfants de comprendre ce qu’est une cellule. Le blob est unicellulaire.
Vendredi 17 Septembre 2021
Genopolys a participé à la demi-journée de nettoyage du campus Arnaud de Villeneuve.
Mardi 21 Septembre 2021
Troisième séance du projet #EleveTonBlob
Une troisième séance s’est déroulée à St Paul et Valmalle en présence de Dorothée Varachat et des enfants de CM1/CM2 avec pour l’animation : Marie Péquignot, Magali kitzmann et Muriel Asari de Genopolys et Chantal Cazevieille de l’INM, pour permettre aux enfants de comprendre la démarche scientifique. Une enquète sur le monde microscopique qui nous entourre a été effectuée par les enfants, avec les controles négatifs, positifs, et les hypothèses scientifiques.
Mardi 28 Septembre 2021
Quatrième séance du projet #EleveTonBlob
Une quatrième séance s’est déroulée à St Paul et Valmalle en présence de Dorothée Varachat et des enfants de CM1/CM2 avec pour l’animation : Marie Péquignot, Magali kitzmann et Muriel Asari de Genopolys, Chantal Cazevieille de l’INM et Pierre Rambeau (docteur en science en reconversion en médiation scientifique), pour permettre aux enfants de comprendre la démarche scientifique. Résultats de l’enquète sur le monde microscopique qui nous entoure. Les hypothèses scientifiques n’étaient pas toujours bonnes, l’erreur en science est tout à fait normale, il suffit de la comprendre pour la rectifier. Les enfants, par groupe de 3, ont également pu s’occuper d’un blob et lui permettre de grandir afin d’effectuer des mesures pour préparer les expériences à lancer pour la grande expérience nationale #Elevetonblob, la semaine du 11 octobre.
Août
Jeudi 26 Aout 2021
Tournage d’un faux plateau télé de chaine d’information en continu
3 doctorants qui ont suivi la formation « osez la médaition scientifique » que Genopolys a proposé pour le collège doctoral en avril 2021, ont accepté de mettre en pratique leur projet de médiation scientifique concu lors de la formation. Jean-Christophe Perez, Morgane Garreau et Amandine Amalric proposent donc une Murder Party sur la thématique de l’esprit critique. Cette murder party sera proposée aux Master 1 qBio (Quantitative Biology) de l’I-SITE MUSE, https://formations.umontpellier.fr/fr/formations/master-XB/master-biologie-sante-KJMN3CNB/quantitative-biology-qbio-KKIAN0V0.html). Les énigmes à résoudre sont des énigmes basées sur de la biology, de l’imagerie et des mathématiques. Les étudiants du Master qBio, devront par la résolution de ces énigmes, comprendre pourquoi un individu suspect déambulait dans l’hopital en émettant des grognements. Afin de situer le sujet avant le début de la murder party, un tournage a eu lieu à Genopolys, ce tournage simule un plateau télé d’une chaine d’information en continu avec ses « spécialistes » et ses « experts » qui débattent sur la vidéo devenue virale sur les réseaux sociaux, montrant cet individu suspect, qui était hospitalisé, qui venait d’etre vacciné contre le rhinoceropopothamovirus et qui a disparu. Les étudiants du Master qBio devront en résolvant les énigmes déméler le vrai du faux.
Jean-Christophe Perez a écrit le scénario et les dialogues du film, a été responsable de sa mise en scène et de son montage. les acteurs du film : Jean-Christophe Perez, Morgane Garreau, Amandine Amalric, Marie Péquignot (Genopolys) et Muriel Asari (Genopolys) ; cameraman : Magali Kitzmann (Genopolys)
Juillet 2021
Congrès des coordinateurs du dispositif « Apprentis Chercheurs » de l’Arbre des Connaissances, en visioconférence. Marie Péquignot et Magali Kitzmann y ont participé.
Juin 2021
Mardi 15 Juin 2021 à 13h30 :
Daniel Rajaonarivelo a brillamment passé son oral de soutenance de stage à l’IUT de Montpellier
Vendredi 18 Juin 2021 à 14h00 :
Présentation des projets retenus dans le cadre de la Qualité de Vie au Travail (QVT) du CNRS (en visoconférence). L’escape game « sens dessus dessous » a été retenu, financé et fait partie des 8 projets « coup de coeur » du CNRS. Lancement dernier trimestre 2021 de cet outil de team building pour les personnels de recherche du campus Arnaud de Villeneuve)
https://blog-rh.cnrs.fr/appel-a-projets-qualite-de-vie-au-travail-41-projets-laureats/
Lundi 21 Juin 2021 à 10h00 :
Le jeu « L’anniversaire de papy en temps de pandémie » a vu le jour dans le cadre du festival Inserm Insciences :
La fameuse pandémie mondiale, dont on nous rabat les oreilles depuis trop longtemps, continue pourtant de susciter indignation, énervement, frustration, découragement, doute et questionnement. Difficile de ne pas parler de cette pandémie quand on est un professionnel de la médiation scientifique.
Oui mais comment aborder ce sujet épineux ?
Comment donner des conseils sans paraitre moralisateur ?
Comment donner envie de s’intéresser à ce sujet déjà traité quotidiennement ?
L’idée
À Genopolys, nous avons décidé d’aborder la question sous forme ludique, l’anniversaire de papy en temps de pandémie est donc avant tout un jeu. Afin qu’il puisse être accessible au plus grand nombre, nous avons fait le choix d’un jeu numérique sur une page web sans téléchargement nécessaire. Le thème du jeu est l’organisation d’une fête de famille en temps de pandémie. Bien entendu, impossible de se lancer dans la conception d’un jeu numérique sur un sujet scientifique sans scientifiques, développeur et web designer.
Voici donc le noyau dur des concepteurs du jeu, permettant de lui garantir son fond et sa forme :
Les concepteurs du jeu :
Le contenu scientifique de ce jeu se devait d’être irréprochable. Les contenus pédagogiques ont donc été scientifiquement validés par deux chercheuses et une Docteure en virologie (Magali Kitzmann, Marie Péquignot et Tania Louis (voir ci-dessus)) ainsi que par des spécialistes, médecins et chercheurs qui ont accepté de répondre à des questions sous forme de courtes vidéos (Michelle Kelly-Irving (chercheuse Inserm, C.E.R.P.O.P (Inserm/Université Toulouse 3 Paul Sabatier)), Franck Molina (chercheur CNRS, directeur Sys2Diag (CNRS, Alcen)) et Vincent Willems (médecin réanimateur, CHU Montpellier)).
Les sources
Toutes les ressources pédagogiques peuvent être consultées indépendamment du jeu et tout au long du jeu, en cliquant dans les « antisèches de Séverine ».
Les vidéos et les infographies :
Le design
Nous souhaitions que ce jeu ait une identité visuelle esthétique et originale, Caroline Constant a su donner vie à une famille très attachante, avec une qualité artistique incontestable et un excellent choix de couleurs chatoyantes. Les infographies et les vidéos qui accompagnent le jeu sont également d’une grande qualité (Houssam Harfouche, musicien et vidéaste indépendant, a filmé et monté la vidéo sur le toucher. MindProd, agence de communication vidéo à Montpellier, représentée par Kévin Wisniewski et Roseline Grandjean, a filmé et monté les interviews des experts scientifiques du projet. Le Quai des savoirs nous a ouvert ses portes toulousaines pour filmer un de ces échanges).
Le jeu
La programmation de ce jeu par Daniel Rajaonarivelo a demandé énormément de temps et de patience. Les joueurs habitués aux jeux vidéo pourraient être déçus par le manque d’animations 2D ou 3D, mais ce choix a l’avantage de garantir un jeu jouable par tous, quel que soit l’équipement informatique. Même si le joueur pense tout connaitre sur la COVID-19, les antisèches de Séverine restent très intéressantes et instructives à consulter.
Développement et fonctionnalités
En plus d’être ludique, des touches d’humour disséminées dans le jeu permettent de rendre l’expérience agréable, en dépit de la thématique. La souris scientifique Séverine teste l’être humain, ses mimiques sont adaptées aux réponses données. Soyez donc attentifs à sa tête qui n’est pas figée, notamment avec la jauge de risque !
Les 3 états de Séverine, la souris scientifique.
Et jouez en mettant le son, le bruitage étant différent en fonction des réponses choisies !
Le jeu reste simple, avec le joueur qui incarne une famille surveillée de près par la souris scientifique Séverine et qui répond à des questions quant aux modalités pratiques du déroulement de la fête de famille. Voir les règles du jeu. Mais ce format, qui peut sembler anodin, permet d’aborder des notions essentielles à la prévention contre ce virus, comme le lavage des mains (petite expérience peu ragoutante à l’appui !), les aérosols (ou pourquoi le masque sous le nez n’est pas efficace ?), ou le principe de la vaccination (comment armer nos globules blancs !). Ces explications et conseils sont donnés au travers d’infographies et de vidéos courtes et sur un ton léger à propos de l’apéritif et de l’extinction des bougies d’anniversaire, notamment. La roue de la santé (petit clin d’œil à certains jeux télévisés) permet de représenter la part « de hasard » qui réside dans toute contamination, et qui reste indépendante de tout comportement. Ainsi ceux qui répondent aux questions dans l’unique but d’échapper à une contamination, peuvent tout de même se retrouver contaminés et frustrés, comme dans la vraie vie.
La Roue de la Santé.
Ce jeu est doublement interactif dans la mesure où les joueurs peuvent revenir en arrière pour modifier leurs réponses et que la réponse de chaque joueur est comparée à celle de tous les autres joueurs (cliquer sur que risquons-nous ?). Nous ferons un bilan des réponses des joueurs lorsque ce jeu ne sera plus d’actualité et que la pandémie sera derrière nous.
Toujours d’actualité
Ce travail collaboratif a pris plusieurs mois et au début de l’aventure, avec le début de la vaccination, nous nous demandions si les gestes barrières et la distanciation ne seraient plus que de lointains souvenirs à l’arrivée de l’été 2021… c’était sans compter sur le variant Delta…
Ainsi pour la rentrée scolaire 2021, le questionnement sur les enfants et leur contagiosité reste totalement d’actualité : Enfants et covid
Sans parler de la balance bénéfice/risque des vaccins sans cesse remise en cause : Vaccination
Il est également important de se rappeler qu’un passage en service de réanimation n’a rien d’anodin : Réanimation
Nous espérons que vous prendrez du plaisir à jouer, tout en comprenant pourquoi, après 18 mois de pandémie, tout rassemblement entre êtres humains doit encore se faire avec beaucoup de précautions.
Pour jouer c’est ici !
Mercredi 30 Juin 2021
Fin de stage pour Daniel Rajaonarivelo, bravo pour tout le travail fourni pour le développement du jeu « l’anniversaire de papy en temps de pandémie ».
Mai 2021
3 mai 2021
Tournage à Genopolys ! Marie Péquignot a expliqué comment marche un oeil, tout en montrant comment en fabriquer un modèle simplifié avec des matériaux de fonds de tiroir. Un projet réalisé par Genopolys, en collaboration avec Claudia Pereira, du service communication de l’Administration déléguée Inserm, Mind Prod était derrière la caméra. Sortie en juin 2021 sur Youtube, dans le cadre du Festival InScience de l’Inserm.
5 mai 2021
Nouveaux tournages à Genopolys ! Vincent Willems (médecin réanimateur CHU Montpellier) et Franck Molina (chercheur CNRS et directeur de Sys2diag (CNRS/Alcen)) sont venus partager leur expertise pour un des projets de Genopolys en cours : L’anniversaire de Papy en temps de pandémie ! (sortie le 21 juin 2021 !).
Les 18, 19 et 20 mai 2021
Une formation « osez la médiation scientifique » pour les doctorants (école doctorale CBS2) a été proposée par Magali Kitzmann et Marie Péquignot, pour la première fois depuis 1 an en présentiel !
8 doctorants ont participé à cette formation dont voici le programme :
Programme détaillé :
Jour 1 (7h) : la médiation scientifique d’un point de vue technique et pédagogique, quel contenu pour quel public ?
Présentation et test de différents supports, mise en situation (jouer à des jeux vidéo, résoudre des énigmes d’escape game, tester des ateliers scientifiques, voir des extraits de films et des teasers). Aborder les notions d’évaluation de chaque action de médiation scientifique.
Jour 2 (7h) : Quelle médiation scientifique me correspond le mieux ?
Matinée : Conception d’animations scientifiques individuellement ou à plusieurs (les formatrices restent présentes pour répondre aux questions et apporter de l’aide si besoin).
Après-midi : mise en pratique des animations conçues devant tout le groupe, présentation des animations proposées par les doctorants, suivies d’une discussion. Évaluation des propositions sur le contenu scientifique (qui doit être compréhensible par tous), l’adéquation de l’action prévue par rapport au public visé, la faisabilité du projet (moyens humains, techniques et financiers).
Jour 3 (7h) :
Matin : La désinformation, en règle générale et durant la crise sanitaire. Exemple d’un film réalisé par une classe de lycéens.
Après-midi : Médiateur scientifique, un métier : discussion et explications des différents parcours . Proposition de participation au Module 2.
Equipe pédagogique :
Dr Magali Kitzmann, chercheuse CNRS, responsable culture scientifique à Genopolys. magali.kitzmann@genopolys.fr, 06 60 76 66 40
Dr Marie Péquignot, chercheuse Inserm à l’Institut des Neurosciences, Médiatrice scientifique à Genopolys. marie.pequignot@inserm.fr
Les matinées des 26, 27 et 28 mai 2021 et les matinées du 1, 2 et 3 juin 2021
Une formation « osez la médiation scientifique » pour les personnels de recherche CNRS avec la délégation Alpes du CNRS, proposée par Magali Kitzmann en distantiel !
6 personnes ont participé à cette formation. L’ auditoire qui a écouté avec attention les présentations des projets de médiation scientifique était composé de : Julien Delahaye, un chercheur investi dans la médiation ; Pascale Carrel, responsable du service communication de la délégation Alpes du CNRS ; Emmanuel Laisne, Chargé de projet ingénierie culturelle à la Casemate et Patricia Roussin.
Jeudi 27 mai 2021 à 15h45
Marie Péquignot a participé à la journée CBS2 (CBS2 days) en pésentant la médiation scientifique sous toutes ses formes, ainsi que les formations à la médiation proposées par Genopolys.
Samedi 29 Mai 2021 de 16h à 18h
L’association Kimiyo propose des animations dans les médiathèques de la Communauté de Communes Val d’Hérault. Ce jour, la médiathèque était celle de Vendémian, et le thème était l’audition, un thème cher à Genopolys ! L’animation a été réalisée par Enzo Blondeau, de Kimiyo, et Marie Péquignot, médiatrice scientifique à Genopolys, avec les supports de Genopolys, pour une quinzaine de personnes. C’était un réel bonheur de reprendre les ateliers en présentiel !
Avril 2021
1 avril 2021
Le rapport d’activité 2020 de Genopolys vient de sortir :
https://www.genopolys.fr/administrator/index.php?option=com_content&view=article&layout=edit&id=241
Ce même jour, Marie Péquignot a effectué un vol zero G pour le projet Parabole réalisé conjointement avec Genopolys, le CNES et le Lycée Jean Monnet. Retrouvez toute l’aventure sur https://www.genopolys.fr/index.php/activites-grand-public/autres-manifestations/242-une-aventure-de-mediation-scientifique-avec-le-lycee-jean-monnet-la-physiologie-en-impesanteur
12 avril 2021
Daniel Rajaonarivelo de l’IUT Informatique de Montpellier vient de débuter son stage à Genopolys, en vu de la programmation d’un jeu numérique pédagogique sur la COVID-19 : « l’anniversaire de papy en temps de pandémie », affaire à suivre.
13 et 14 avril 2021
Magali Kitzmann et Marie Péquignot ont animé une formation Partage de Sciences pour 7 doctorants du Collège Doctoral de l’Université de Montpellier. https://collegedoctoral.umontpellier.fr/
Dans le contexte de crise sanitaire, elle s’est faite une fois de plus en distanciel.
Mars 2021
23 mars 2021
L’escape game « sens dessus dessous » n’a pas obtenu suffisamment de votes citoyens pour etre financé! les familles d’Occitanie ne profiteront pas de cet escape game. Linotte est triste!
30 mars 2021
Formation DDCS 34, « culture scientifique » conjointe entre Genopolys (Magali Kitzmann), Kimiyo (John Bandelier) et Planète sciences (Michel Houques).
Février 2021
Habitants d’Occitanie, votez pour le projet de Genopolys!!!
(du 12 février 2021 au 15 mars 2021)
Genopolys participe à la région citoyenne en proposant son escape game dans « vos solutions pour la culture ». De la culture scientifique dans les projets culturels. Un jeu d’enigmes familial sur les sens concu par des chercheuses. Un moyen d’oublier la morosité ambiante. Une reprise en main de ses sens (y compris le toucher!). De la bonne humeur. L’apprentissage des sciences derrière les sens. Une itinérance permettant de toucher le public Occitan en zone rurale.
le projet : https://jeparticipe.laregioncitoyenne.fr/projects/budget-participatif-culture-2020-occitanie/collect/depot-des-candidatures/proposals/sens-dessus-dessous-un-escape-game-de-mediation-scientifique-itinerant-convivial-et-intergenerationnel
s’inscrire pour voter : https://www.laregioncitoyenne.fr/auth/realms/laregioncitoyenne/protocol/openid-connect/auth?client_id=lrc-meteor&redirect_uri=https://www.laregioncitoyenne.fr/MonProfil&state=78764983-4565-4d4f-9d28-3b9877f5adeb&nonce=182be346-817c-49c6-849f-627a08f8a836&response_mode=fragment&response_type=code&scope=openid
26 février 2021
Hello Labo, disponible au téléchargement sur le site d’ArtFX!
Le jeu vidéo sur deux organismes extrêmophiles, le tardigrade (que l’on trouve partout) et la grenouille Rana Sylvatica (qui survit au grand froid qui sévit aux Etats Unis et au Canada) est disponible. La conception de ce jeu fait suite aux summerchools de 2020 de Genopolys dont la thématique principale était l’étude d’organismes extrêmophiles. Le jeu s’adresse aux enfants entre 9 et 15 ans et est interactif avec possibilité de caresser et nourrir ces deux organismes. Pour cette partie du jeu, les enfants peuvent découvrir les environnements de ces deux extremophiles et de quoi ils se nourrissent. La deuxième partie du jeu consiste à les amener dans un laboratoire et à les soumettre à des températures, hygrométries, pression et rayons UV variables pour connaitre leur degré de résistance. Les enfants pourront savoir comment et quand ces organismes survivent (etat « tun » pour le tardigrade, arret cardiaque et congélation pour la grenouille Rana Sylvatica).
« Hello Labo » a donc vu le jour, pour les enfants, pour smartphones android. Jeu à télécharger : https://artfx-school.itch.io/hello-labo
Janvier 2021
Le jeu vidéo est un secteur qui n’a pas connu la crise en 2020 (https://www.lemonde.fr/economie/article/2020/04/14/covid-19-portee-par-le-confinement-l-industrie-du-jeu-video-en-pleine-euphorie_6036576_3234.html) et qui touche des millions de personnes rien qu’en France. Nous avons continué notre collaboration débutée en 2018 avec l’école de jeux vidéo ArtFX, pour encadrer un groupe d’étudiants en quatrième année, dans la conception d’un jeu vidéo sur deux organismes extrêmophiles, le tardigrade et la grenouille Rana Sylvatica (qui survit au grand froid qui sévit aux Etats Unis et au Canada). La conception de ce jeu fait suite aux summerchools de 2020 de Genopolys dont la thématique principale était l’étude d’organismes extrêmophiles (https://www.echosciences-sud.fr/articles/summerschool-2020). Le jeu s’adresse aux enfants entre 9 et 15 ans et est interactif avec possibilité de caresser et nourrir ces deux organismes, mais également de les amener dans un laboratoire et de les soumettre à des températures, hygrométries, pression et rayons UV variables pour connaitre leur degré de résistance. Pour ce jeu vidéo sur le tardigrade, une présentation sur les extrêmophiles a été faite par Magali Kitzmann en octobre 2020 à l’école ArtFX devant un groupe d’étudiants (Constantin Amouroux, Producer and Ui ; Axel Somsy, Game Designer ; Clara Lopez, game designer ; Thomas Bruyneel, Character Artist ; Allan Magagnoc, Environment Artist ; Paolo Dupuy, Environment Artist ; Guilhem Perez, animation and Rigging) en quatrième année de la section jeu vidéo qui avaient choisi de travailler sur le jeu, encadrés par Agathe Turlotte. Ensuite, chaque semaine une réunion (en visioconférence) entre les étudiants, Agathe Turlotte d’ArtFX, Marie Péquignot et Magali Kitzmann de Genopolys s’est tenue pour suivre l’évolution du jeu vidéo, jusqu’en décembre 2020. L’école Audio Workshop (équipe d’Olivier Penchenier) a également participé à ce projet avec Py Marrec, Thomas Src et Dow Urso pour le Sound design. Thibault Casano, Freelancer a composé les deux musiques qualitatives. Les étudiants d’ArtFX ont également pu poser toutes leurs questions à Myriam Richaud, chercheuse sur le tardigrade (IBMM, Université de Montpellier). »Hello Lab » a donc vu le jour en janvier 2021, pour des enfants de 9 à 15 ans, pour smartphones android.